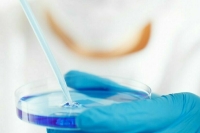
В России не зафиксировали случаи завоза западного энцефалита лошадей

Роспотребнадзор: материалы
Материалы

Виктория Карташева 13.01.2024

Врачи настоятельно советуют россиянам чаще мыть руки и не заниматься самолечением
Анна Шушкина 11.01.2024

Евгения Филиппова 05.01.2024

Алексей Лапшин 04.01.2024

Роспотребнадзор предложил обновить требования к условиям жизни в социальных заведениях
Мария Кузнецова 02.01.2024

В Сибирь — с вакциной от клещевого энцефалита, а в Индию — от брюшного тифа и бешенства
Василиса Киреева 30.12.2023

Виктория Карташева 25.12.2023

Антон Гребенников 22.12.2023

Виктория Карташева 18.12.2023